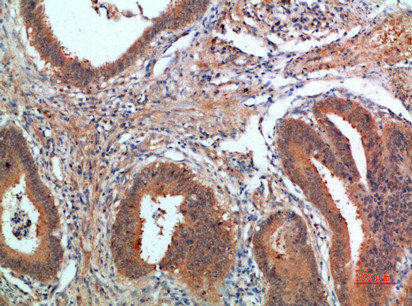
PDGFC Antibody (PACO07374)

| UniProt Protein Function: | PDGFC: Growth factor that plays an essential role in the regulation of embryonic development, cell proliferation, cell migration, survival and chemotaxis. Potent mitogen and chemoattractant for cells of mesenchymal origin. Required for normal skeleton formation during embryonic development, especially for normal development of the craniofacial skeleton and for normal development of the palate. Required for normal skin morphogenesis during embryonic development. Plays an important role in wound healing, where it appears to be involved in three stages: inflammation, proliferation and remodeling. Plays an important role in angiogenesis and blood vessel development. Involved in fibrotic processes, in which transformation of interstitial fibroblasts into myofibroblasts plus collagen deposition occurs. The CUB domain has mitogenic activity in coronary artery smooth muscle cells, suggesting a role beyond the maintenance of the latency of the PDGF domain. In the nucleus, PDGFC seems to have additional function. Belongs to the PDGF/VEGF growth factor family. 3 isoforms of the human protein are produced by alternative splicing. |
| UniProt Protein Details: | Protein type:Secreted, signal peptide; Secreted Chromosomal Location of Human Ortholog: 4q32 Cellular Component: cell surface; cytoplasm; endoplasmic reticulum lumen; extracellular region; extracellular space; Golgi membrane; plasma membrane Molecular Function:platelet-derived growth factor receptor binding; protein binding; protein homodimerization activity Biological Process: blood coagulation; central nervous system development; platelet-derived growth factor receptor signaling pathway; positive regulation of cell migration; positive regulation of DNA replication; positive regulation of fibroblast proliferation; positive regulation of MAP kinase activity; positive regulation of phosphoinositide 3-kinase cascade; positive regulation of protein amino acid autophosphorylation |
| NCBI Summary: | The protein encoded by this gene is a member of the platelet-derived growth factor family. The four members of this family are mitogenic factors for cells of mesenchymal origin and are characterized by a core motif of eight cysteines. This gene product appears to form only homodimers. It differs from the platelet-derived growth factor alpha and beta polypeptides in having an unusual N-terminal domain, the CUB domain. Alternatively spliced transcript variants have been found for this gene. [provided by RefSeq, Sep 2010] |
| UniProt Code: | Q9NRA1 |
| NCBI GenInfo Identifier: | 205830662 |
| NCBI Gene ID: | 56034 |
| NCBI Accession: | Q9NRA1.2 |
| UniProt Secondary Accession: | Q9NRA1,Q4W5M9, Q9UL22, B4DU34, B9EGR8, |
| UniProt Related Accession: | Q9NRA1 |
| Molecular Weight: | 20,609 Da |
| NCBI Full Name: | Platelet-derived growth factor C |
| NCBI Synonym Full Names: | platelet derived growth factor C |
| NCBI Official Symbol: | PDGFC |
| NCBI Official Synonym Symbols: | SCDGF; FALLOTEIN |
| NCBI Protein Information: | platelet-derived growth factor C |
| UniProt Protein Name: | Platelet-derived growth factor C |
| UniProt Synonym Protein Names: | Fallotein; Spinal cord-derived growth factor; SCDGF |
| Protein Family: | Platelet-derived growth factor |
| UniProt Gene Name: | PDGFC |
| UniProt Entry Name: | PDGFC_HUMAN |